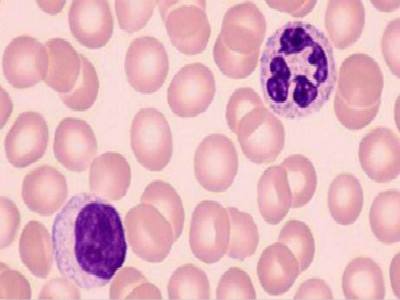

文章来源:未知 发布时间:2019-10-18 10:27
在我们的日常生活中过敏性紫癜是比较常见的,但是导致过敏性紫癜的原因想必大家都不知道,那么过敏性紫癜的引发原因是什么,其实过敏性紫癜的症状有很多,发病机制也是不一样的,下面上海紫癜疾病研究院就此问题给大家做出了分析。
西医上都认为过敏性紫癜的发病时由于免疫力的紊乱和外部病毒的入侵引起了自身免疫力出现了问题导致的,他会到直接血管受伤,出现全身紫癜的情况,外部说的病毒入侵的原因其实很普通,可能是花粉,可能是食物,都有可能诱发紫癜。
所以很多容易过敏的体质人群请尽量不要接触过敏源,花粉之类的物体,食物上像海鲜、蛋白质较高的食物也尽量不要食用,另外的一个原因可能是因为服用了抗生素和上呼吸道感染一类的食物。
根据临床医学的研究发现,这是一种血液类疾病,是人体的免疫力上发生了损伤或者是缺陷导致的,人体的最初步免疫系统是皮肤和黏膜,人体的最初保护就是皮肤,一旦皮肤发生了损伤感染,就可能导致过敏性紫癜的发生,也就是过敏性紫癜可能是通过皮肤黏膜进行传播的。
那么我们知道了过敏性紫癜的引发原因,那怎么治疗过敏性紫癜呢,治疗过敏性紫癜其实并不复杂利用上海紫癜疾病研究院的超氧抗体激活疗法就能有效的治疗紫癜,超氧抗体激活疗法是一个中西医结合的疗法,用医疗设备进行表面感染处的病毒清除和修复,再用专利的中医药物进行免疫力修复等等,以达到痊愈的目的
上面就是给大家介绍的过敏性紫癜的引发原因是什么和紫癜的治疗方法,希望可能给您带来帮助,有凭什么不懂的可以咨询我们的在线专家团队。
通过主诊医师的细致问诊、看诊、听诊,并结合专业仪器的检查结果,确定过敏性紫癜病人的病情程度以及病症分型,个人体质、免疫、血管、肾脏损害情况等。
结合患者自身情况,根据需求安排患者接受规范化检查,内容包括:血常规、尿常规、血管脆性检查、免疫检查、腹部B超检查、胃肠镜检查、肾穿刺检查等。
主诊医师应根据检查结果和病人自身的实际情况,运用中西医结合创新诊疗技术,分型对症论治,内调外治,规范治疗,规范用药,提升整体治疗效果。
为响应相关政策号召,我院开通多种渠道方便病人预约就诊。
上海市浦东新区川沙路4629弄50号
021-66790795
QQ:277335818